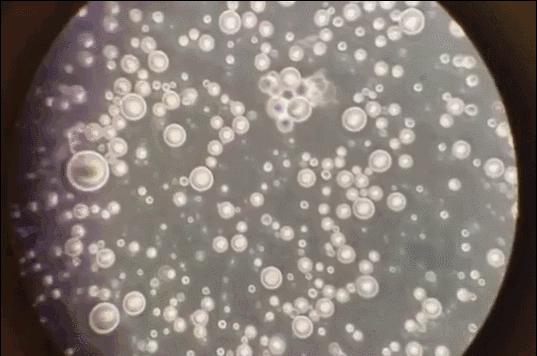
“母乳”放大1000倍，堪称世间最纯净液体

人们常说,孩子喝母乳要比喝奶粉好,但每次提到这一话题,都有一大堆“高尚人士”站出来大肆批判,说母乳喂养被过度夸大,还拿现实举例,表示很多孩子都是喝奶粉长大的,不照样没事么,这足以证明母乳与奶粉的差别并没有想象中那么大。

那么,事实真相到底是什么样子呢?
有网友将母乳放在显微镜下观察,看似稀疏平常的母乳被放大1000倍之后,呈现出非同一般的特性。
首先是纯净度,除了营养物质之外,我们几乎没找到任何“杂质”,这代表着它对孩子完全无害。要知道,哪怕是现场抽出来的人体血液,也难免掺杂一些“代谢废料”,这几乎是不可避免的。而母乳如此纯净,无愧于人们大力推崇它,配得上其身份地位。

其次是营养物质,显微镜下,无数圆形小颗粒清晰可见,它们虽然大小不一,但分布还算规律,更神奇的是,微微颤抖着,这些营养物质竟然活了,而反观配方奶在显微镜下则没有这些活物。
看到的这些营养是满满的脂肪粒,在其中蕴含着各种营养元素,足以支撑宝宝的健康发育。那些“活着”的营养中满满都是活性蛋白,这也是奶粉无法比拟的“短板”。

母乳和配方奶究竟区别有多大?对比之下高低立现
总有人拿“喝奶粉也能健康长大”来抬高奶粉的地位,殊不知没有任何一家奶粉品牌敢说,自己奶粉与母乳没有任何区别,它们制作奶粉的最主要原则之一就是“尽可能复原母乳”。
生厂商都不敢保证的东西,身为局外人,居然敢怒怼大众,未免有些可笑。相对于奶粉,母乳无论是在成分上还是在作用上,优势都非常大,完全不是一个等级:
研究显示,母乳中中含有200多种营养物质,而奶粉中只有不到一半,不是不想往里加,而是以目前的科学技术,很多东西完全加不进去。

母乳中的活性免疫蛋白,能极大提高孩子的免疫力,奶粉中完全不存在,随着孩子的生长发育,母乳会自发性调整成分占比,而奶粉只能靠家长更换,效率低了不止一筹。
喝母乳的婴儿,经常会出现攒肚现象,这是吸收效率高的表现,而奶粉喂养却常常出现便秘……
不难看出,奶粉根本不可能比得上母乳,在现实的对比面前,营养差异高低立现。
母乳喂养是人类几千年来得以传承的本能
母乳喂养是人类几千年来得以传承的本能,也是哺乳动物进化完善生理机能的最高表现。但现在似乎有被奶粉颠覆的趋势。妈妈们可以超越母乳喂养这个法则使用替代品喂养,这是一种违背自然进化的人为退化。
中国的妈妈几乎都会买奶粉。有的是妈妈没有奶;有的是妈妈奶水不足;在现有生活条件下,更多的是妈妈奶水很多,多得可以同时去当奶妈。无论哪种情况,她们都要买奶粉。使拥有几千万待哺婴幼儿的泱泱大国的市场得到无限制的扩展。有一份报告说:2011年我国每年递增的“干乳制品的产量就已超过了300多万吨”,而“婴幼儿配方奶粉产量也已经达到60多万吨”,仍然存在巨大潜力。

妈妈们为什么如此崇信奶粉,以至于敢冒不断出现的安全风险、敞开腰包挺进市场?难道说生活水平大大提高的现代妈妈的乳液真的不行了?已经比不上用牛奶(或羊奶)通过人工合成的奶粉?完全不是!而是人们耐不住也已经非常习惯了听从媒体铺天盖地的宣传的结果,她们崇信的是谋利的媒体和暴利的商家那些诱人的广告:

“奶粉中含有婴儿成长需要的各种营养”;
“配方奶是宝宝健康成长需要的营养素的重要来源之一”;
“婴儿奶粉中各主要营养素含量和成分组成对婴儿生长发育过程中起到重要的作用与影响”;
奶粉是“新的爸爸、新的妈妈抚育宝宝的好帮手”。

一个妈妈,敢于放弃对子女的“养”、“育”的天然义务和社会责任,让奶粉替代母乳,不是健康妈妈而只是一些特殊的母亲才会做出这种无奈选择。几千年来,母乳喂养都是妈妈功德无量的伟大使命、更是人类进化中永恒的法则。
妈妈们,放弃时尚,返璞归真,重新回归自然纯朴的母乳喂养。让你的孩子从出生那一刻起就喝上最安全的天赋营养品,享受大自然赋予的幸福!用甘甜的母乳哺育伟大的母爱,用浓浓的乳汁浇灌高山大海一样的亲情。